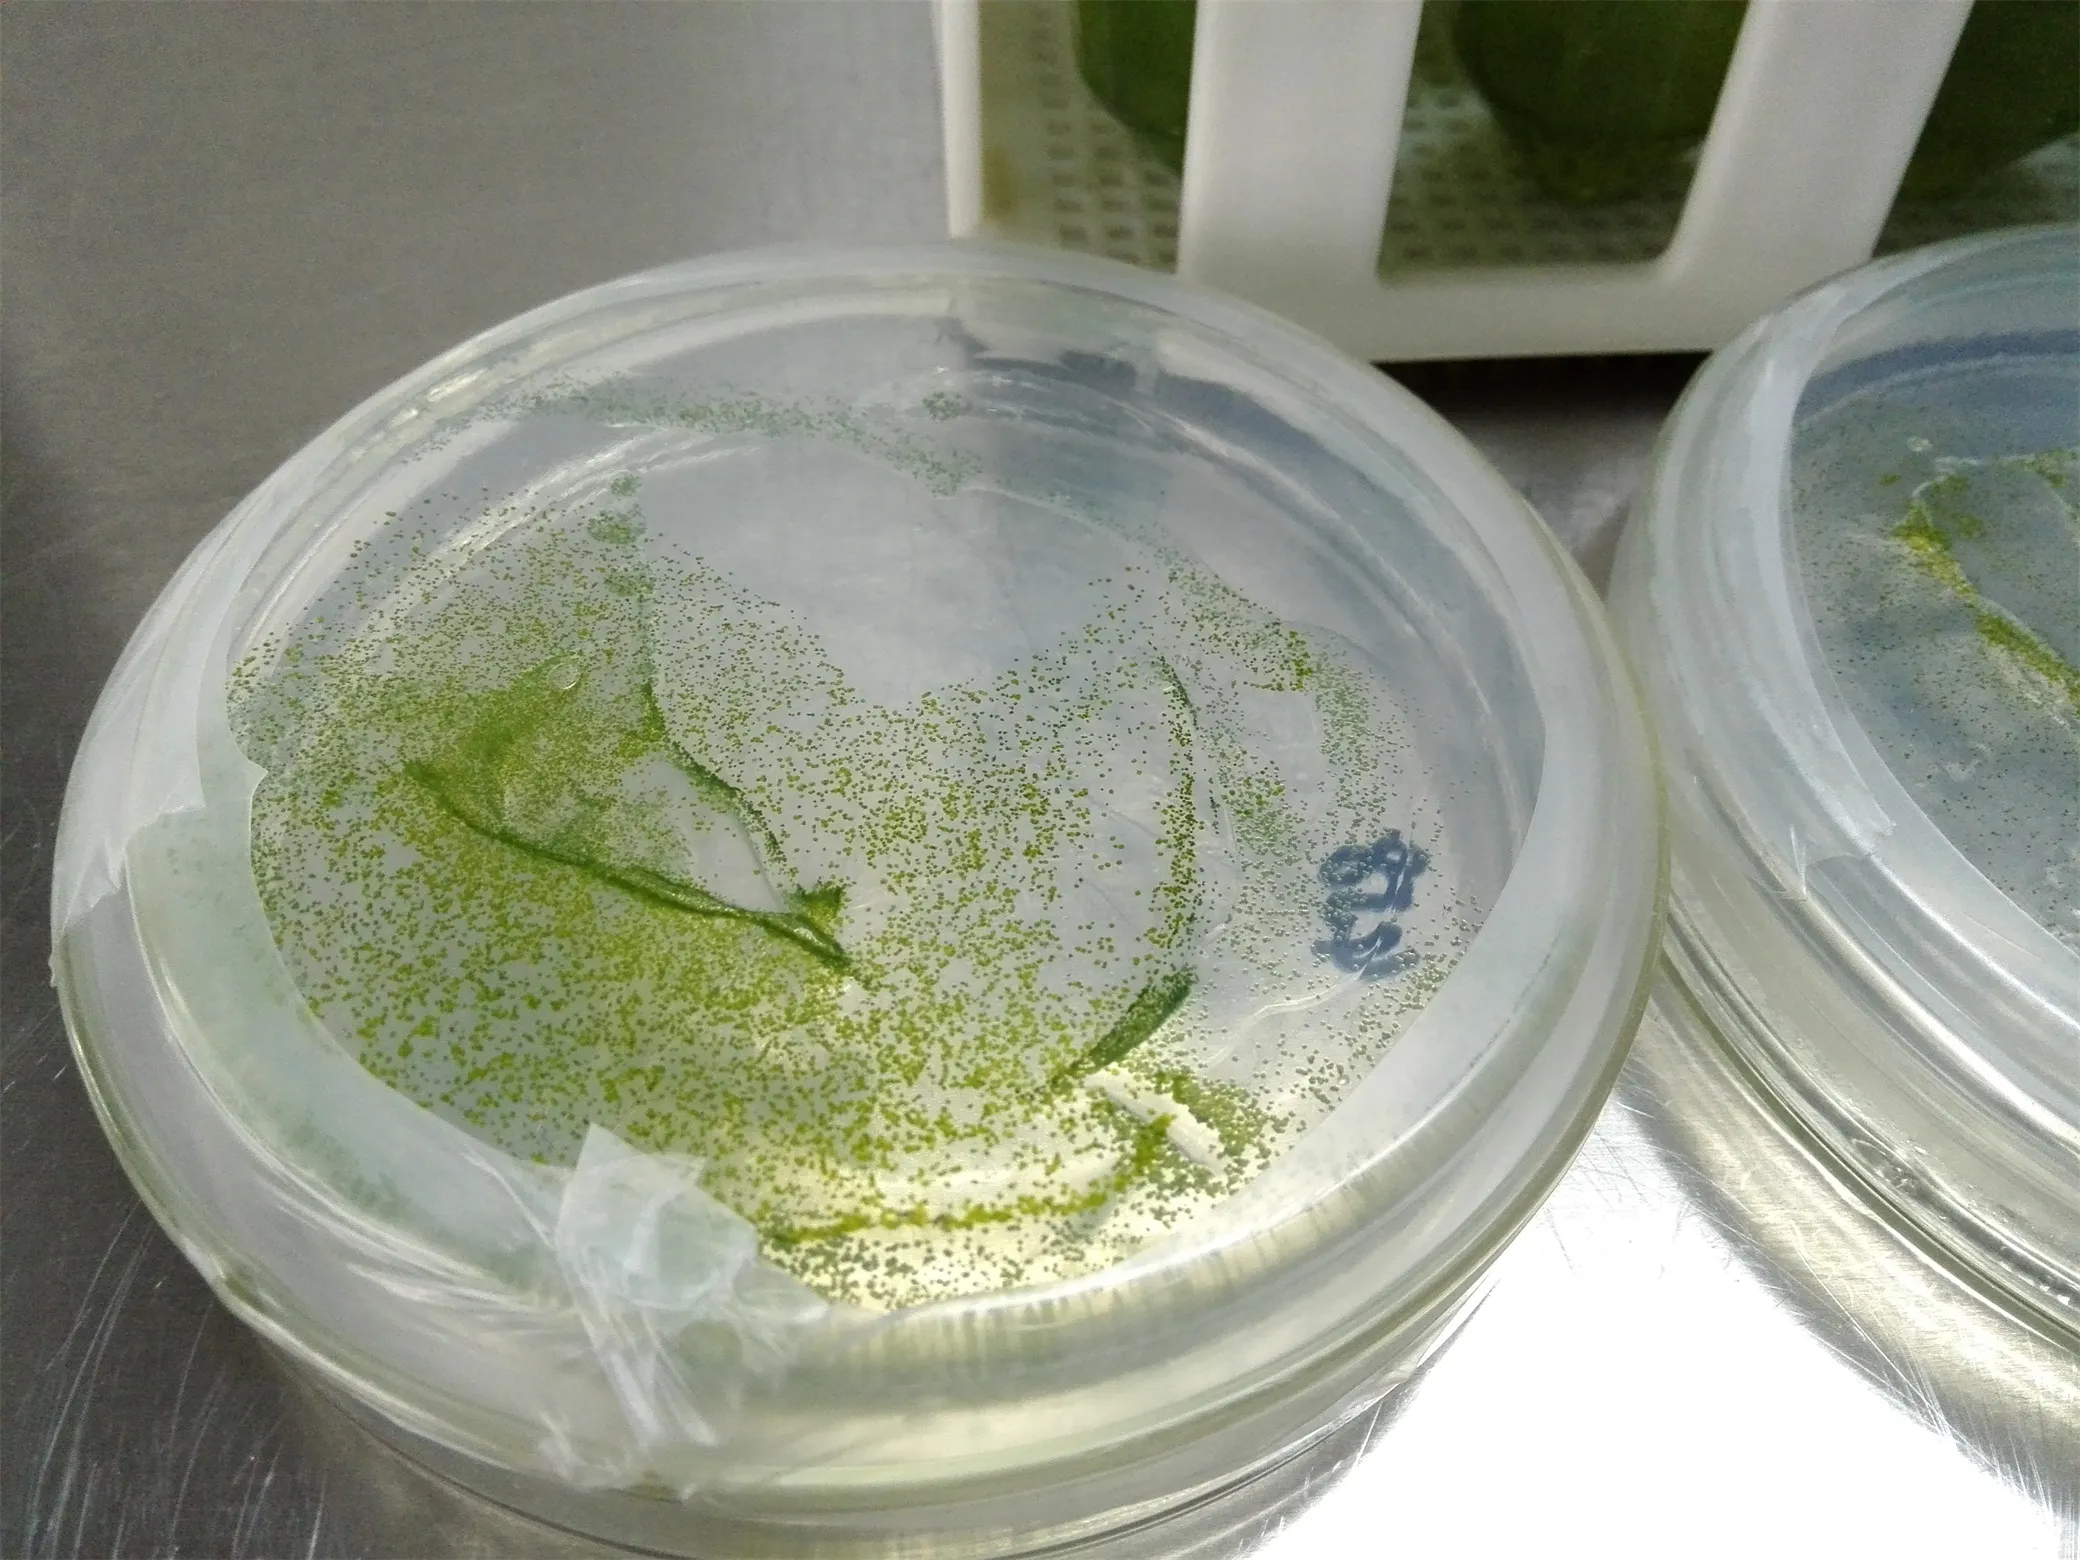
雨生红球藻平板涂布

欢迎关注光语生物的藻类培养基产品,若您购买之前未接触藻类培养技术,可以先向我们的客服(100@leadingtec.cn)索取藻类培养的一些免费资料和教程。
鉴于单细胞藻类的转基因和活性物质提取等实验的严格要求,越来越多客户倾向于使用固态平板或斜面进行单细胞藻类培养和试验。
目前本公司推出多种藻类浓缩培养基(f/2-Si,f/2+Si,K-medium,SE-medium,BBM,cBBM,BG11,Tap-medium,Waris-H,土壤提取液等)和淡水、海水藻类固态培养基工作液,亦可根据要求私人定制。
| 货号 | 归类 | 品名 | 规格描述 |
| GY-M06-A200 | 培养基 | 淡水藻类纯化 | 200ml |
| GY-M06-A500 | 培养基 | 淡水藻类纯化 | 500ml |
| GY-M06-B200 | 培养基 | 海水藻类纯化 | 200ml |
| GY-M06-B500 | 培养基 | 海水藻类纯化 | 500ml |
| GY-M06-C200 | 培养基 | 淡水藻类保藏 | 200ml |
| GY-M06-C500 | 培养基 | 淡水藻类保藏 | 500ml |
| GY-M06-D200 | 培养基 | 海水藻类保藏 | 200ml |
| GY-M06-D500 | 培养基 | 海水藻类保藏 | 500ml |
可以满足客户特殊要求:同位素营养盐、特殊藻株纯化等
固态培养基适用于淡水、海水微型藻类的纯化及保藏。已测试除甲藻之外的其他常见藻类,性能优良。此产品主要分两种类型:藻类纯化培养基和藻类保藏培养基。又分为淡水和海水两款。
每款培养基分为两部分:灭菌封装的凝固琼脂混合物(简称主体)和2-4种辅助试剂(无菌封装)。
您可以根据实验用量选择200mL或500mL的产品。(参考量: 200mL培养基可以做直径6mm平板20个左右,直径10mm平板15个左右;)
使用方法:培养基为无菌封装,收到培养基后可冷冻保存两周左右,亦可直接拧松主体的盖子并微波加热熔化,或120度高压灭菌25-30分钟(推荐);灭菌完成后请拧紧盖子,在超净台下冷却至30度左右(不烫手即可),加入全部辅助试剂、混匀,于酒精灯无菌圈范围内制作平板或斜面;用接种环刺穿培养基表面划“Z”或“井”字线,或用涂布棒涂布平板;封口,置于培养箱培养,避免光线直射。
注意事项:
- 本产品为工作液,不建议勾兑或稀释;
- 本产品为无菌封装,产品拆封和平板制作、划线、涂布须在无菌条件下操作;
- 固态培养基营养丰富,保质期较短。请尽量一次用完,剩余的产品再次熔化,部分成分可能失效;
- 平板制作前,建议使用本公司的藻类培养-除菌/抑菌系列产品(Cell Purification reagents),去除细胞表面和培养液里面的大多数细菌,对细胞进行初步纯化。
- 本产品为本公司独家研发的专利产品,经数年改良和测试,暂时不提供母液产品和配方。

评价
目前还没有评价